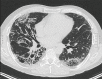

The 8th lung cancer TNM classification and clinical staging system: review of the changes and clinical implications
- PMID: 30211037
- PMCID: PMC6127520
- DOI: 10.21037/qims.2018.08.02
The 8th lung cancer TNM classification and clinical staging system: review of the changes and clinical implications
Abstract
Lung cancer is the leading cause of cancer death in both men and women. Clinical staging plays a crucial role in predicting survivor as well as influencing management option in lung cancer patients. Guidelines are constantly being reviewed as more data becomes available to provide the most accurate prognostic markers, hence aiding in the clinical detection and staging of lung cancer. Since its introduction in the 1970s, the TNM staging has undergone significant revisions with the latest, 8th edition, being effective internationally from 2018. This edition re-categorizes the tumour size and other non-quantitative tumour descriptors (T), and further subclassifies extra-thoracic metastases (M). The clinical nodal (N) classifier is unchanged as the earlier version correlates well with prognosis. The downstream effects on staging to accommodate for the new T and M classifications are highlighted. The survival is inversely proportional to every centimeter increase in tumour size up till 7 cm, where the same prognosis as a T4 disease is reached. Hence, some of the T-classifiers based on size of the tumour is upstaged to reflect that. Invasion of the diaphragm is considered T4 instead of T3. On the other hand, involvement of the main bronchus regardless of tumour distance to carina as well as atelectasis is down-staged from a T3 to a T2 disease. Since the 7th edition, new entities of lung tumour known as adenocarcinoma in situ (AIS) and minimally invasive adenocarcinoma (MIA) have been introduced. The T-defining features are also described in this manuscript. Extrathoracic metastases that were classified as M1b in the 7th edition is further subcategorized into M1b and M1c in the 8th edition, to better define oligometastasis which has a better prognosis, and may benefit from more aggressive local therapy. This overview aims to provide radiologists with a description of the changes in the latest edition including staging of subsolid and multiple nodules, outline potential limitations of this 8th edition, as well as discussion on the implications on treatment.
Keywords: AJCC; Lung cancer; TNM 8th edition; UICC; malignancy; metastasis; neoplasm; staging.
Conflict of interest statement
Conflicts of Interest: The authors have no conflicts of interest to declare.
Figures

References
-
- Cancer Research UK. Available online: http://www.cancerresearchuk.org/health-professional/cancer-statistics/in..., accessed Dec 2017.
-
- Rami-Porta R, Bolejack V, Giroux DJ, Chansky K, Crowley J, Asamura H, Goldstraw P, International Association for the Study of Lung Cancer Staging and Prognostic Factors Committee, Advisory Board Members and Participating Institutions The IASCL Lung Cancer Staging Project: The new database to inform the eight edition of the TNM classification of lung cancer. J Thorac Oncol 2014;9:1618-24. 10.1097/JTO.0000000000000334 - DOI - PubMed
-
- Goldstraw P, Crowley J. IASLC International Staging Project. The IASLC International Staging Project on Lung Cancer. J Thorac Oncol 2006;1:281-6. 10.1016/S1556-0864(15)31581-1 - DOI
Publication types
LinkOut - more resources
Full Text Sources
Other Literature Sources